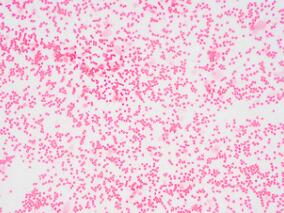
中年男子头晕、乏力1月余 原来是血液病

-
63岁女性右侧颧骨区突出2个月余 一查竟是…
环球医学资讯
2022年11月02日
点击量:401
1小时条评论63岁女性,发现右侧颧骨区突出2个月余,罪魁祸首为...... 患者女性,63岁。 【简要病史】 发现右侧颧骨区突出2个月余。 【PET/CT图像分析】 右上颌窦内软组织肿块,大小约4.9cmtimes;3.5cm,密度不均匀,内见多发斑片状骨质密度影,肿块向外浸润至右颞窝及右颊...
-
男子气短1个月 胸片提示左侧大量胸腔积液 诊断结果…
环球医学资讯
2022年08月31日
点击量:1014
1小时条评论58岁男性,无诱因胸闷气短1个月,并进行性加重,偶有干咳。入院前1天于外院行胸部正位片提示左侧大量胸腔积液征象,未予任何治疗即来笔者医院就诊。询问病史发现,患者13年前因右肾透明细胞癌行右肾根治性切除术(T1N0M0),术后定期监测,病情稳定,未发现转移征象...
-
中年男子胃癌术后5年腹胀难忍 原因何在?
环球医学资讯
2022年08月24日
点击量:432
1小时条评论50岁男性,5+年前行胃癌术,6+个月前出现腹胀不适,进食后明显,伴腹痛、恶心、呕吐数次,呕吐物为胃内容物,呕吐后腹部症状可缓解。如何诊断及对应处理? 主诉:胃癌术后5+年,反复腹胀6+个月。 现病史:5+年前患者因上腹胀痛不适,于外院诊断为胃癌,并行胃大部切除术,术后...
-
老爷爷反复咳嗽咳痰、气短15年 近来症状逐渐加重
环球医学资讯
2022年08月15日
点击量:294
1小时条评论73岁男性,反复咳嗽、咳痰及气短症状15年,冬季好发,每年发病大于3个月,迁延不愈,呈逐年加重趋势,自行吸氧及吸入硫酸沙丁胺醇气雾剂后气短症状有缓解,未住院系统诊治。1年来自觉喘息症状逐渐加重,严重影响日常活动,需卧床休息或吸入硫酸沙丁胺醇气雾剂后可缓...
-
50岁女性胸痛、咳嗽、痰中带血 检查后发现大事不妙
环球医学资讯
2022年08月04日
点击量:316
1小时条评论50岁女性,胸部痛3个月,咳嗽1个月,痰中带血5天。到当地县医院查胸部CT示:①左上肺占位,性质待查:肿瘤?结核?②左侧胸腔积液,行左侧胸腔闭式引流等治疗后症状有所缓解。现患者为明确诊断,来笔者所在医院进一步检查治疗。 主诉:左侧胸背部疼痛3个月,咳嗽、气促1个...
-
中年男子头晕、乏力1月余 原来是血液病
环球医学资讯
2022年08月02日
点击量:331
1小时条评论45岁男性,头晕、乏力1+个月,无潮热、盗汗,无头痛、恶心、呕吐,无畏寒、发热,无咳嗽、咯血,无腹痛、腹泻,遂于当地医院就诊,查血常规:白细胞1.3times;109/L、红细胞3.43times;1012/L,当地医院建议转上级医院进一步治疗。原来是血液系统疾病作祟...... 主诉:头晕、乏力...
-
48岁女性反复恶心呕吐、意识障碍 治疗后症状稍好转…
环球医学资讯
2022年06月22日
点击量:241
1小时条评论48岁女性,恶心呕吐、意识障碍。予以静滴浓氯化钠等治疗(具体不详)后患者症状稍好转。其后患者再次出现上述症状加重伴神情呆滞、意识模糊、自言自语,偶有口角不受控制的抽动。如何诊治? 主诉:反复头晕、恶心、呕吐伴精神行为异常1+个月,加重1天。 现病史:1+个月前...
-
老奶奶突发高热曾被诊为肺炎 原来是“它”捣的乱
环球医学资讯
2022年05月13日
点击量:153
1小时条评论63岁女性,入院前1个月无明显诱因出现发热,最高为39℃,曾于当地医院诊断肺炎,原来是它捣的乱。 nbsp; 【病历摘要】 患者女性,63岁,入院前1个月无明显诱因出现发热,最高为39℃,伴头晕、乏力,咳嗽、咳痰,胸闷、心悸。曾于当地医院诊断肺炎。具体诊治不详且...
-
老爷爷反复鼻塞10年加重伴流涕1年 罪魁祸首为…
环球医学资讯
2022年05月06日
点击量:149
1小时条评论73岁男性,反复鼻塞10年,加重伴流涕1年,罪魁祸首竟为...... nbsp; 患者男性,73岁。 【简要病史】 反复鼻塞10年,加重伴流涕1年。 【实验室检查】 尿轻链(lambda;)正常,尿轻链(kappa;)51.5mg/Luarr;。血清M蛋白分型未见异常区带,kappa;/lambda; 7.15ua...
-
PD-1单抗靶向治疗导致垂体炎 怎么办?
环球医学资讯
2022年03月17日
点击量:2876
1小时条评论随着新型肿瘤免疫治疗在临床的应用增多,PD-1(programmed cell death receptor 1)单抗导致的自身免疫性内分泌腺体炎日益增多,但该类疾病尚不为众多内分泌医生所熟知。现报道1例肾透明细胞癌患者应用PD-1单抗nivolumab靶向治疗后出现垂体炎与垂体功能减退的病例,...

会员登录

